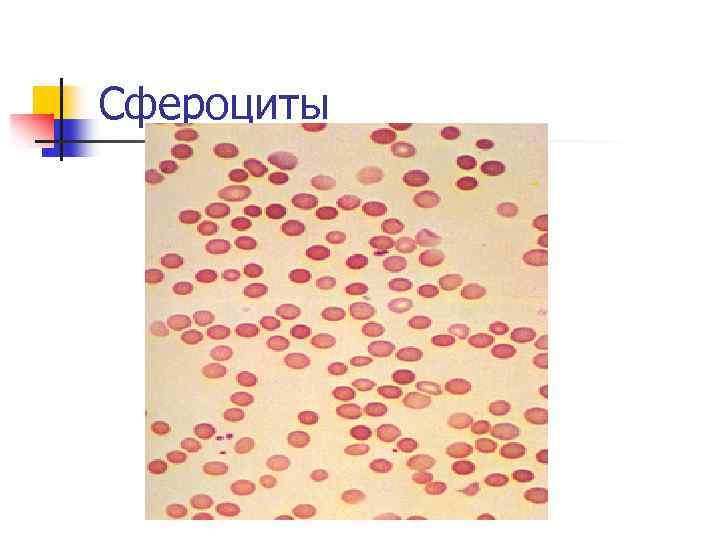
Сфероциты
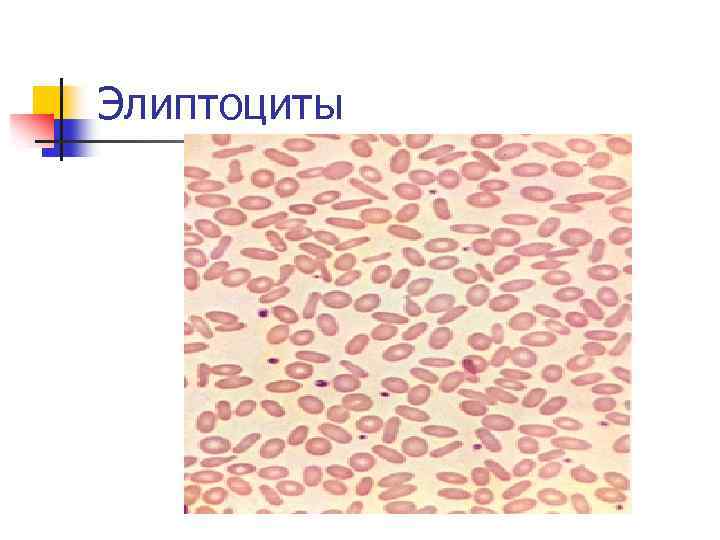
Элиптоциты
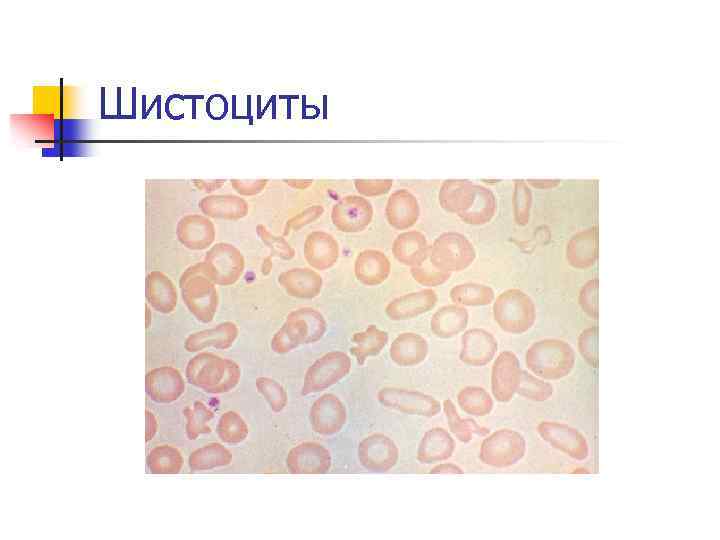
Шистоциты
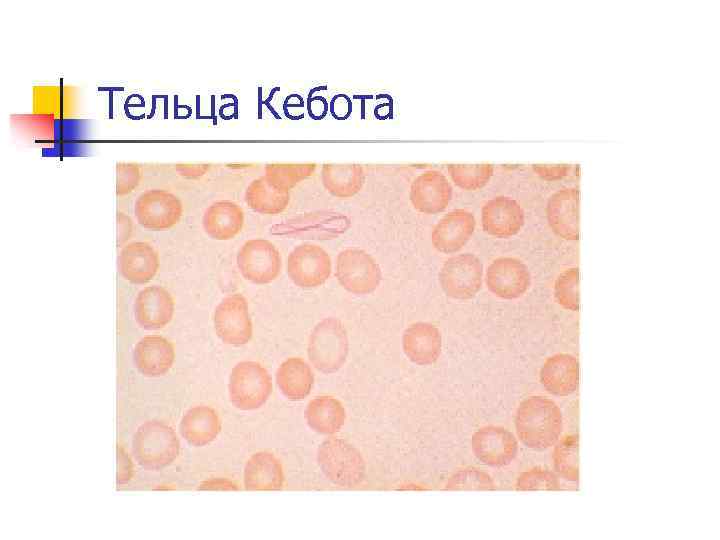
Тельца Кебота
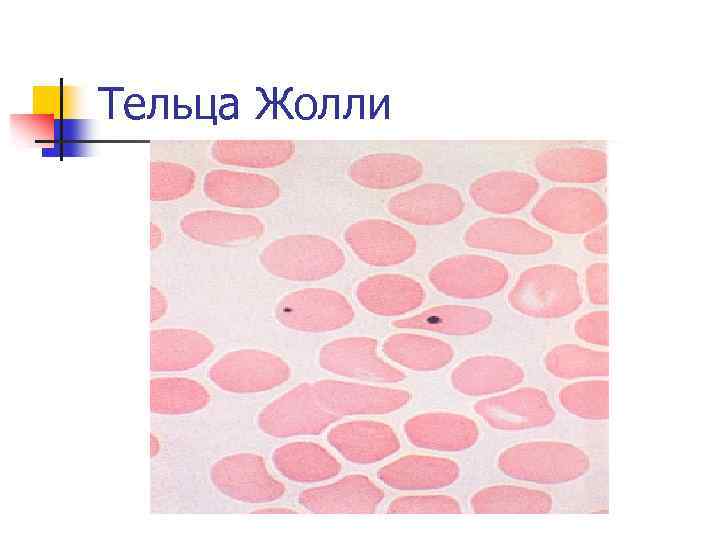
Тельца Жолли

анемии у детей2 (лекция).ppt
- Количество слайдов: 97
 Анемии у детей К. м. н. Романова О. Н. ГУ «РНПЦДОГ» , БГМУ, кафедра детских болезней № 1
Анемии у детей К. м. н. Романова О. Н. ГУ «РНПЦДОГ» , БГМУ, кафедра детских болезней № 1
 Цель лекции: n Ознакомить с анемическим синдромом у детей, классификацией, диагностикой, клиникой и алгоритмами диагностики анемий у детей в зависимости от этиологии.
Цель лекции: n Ознакомить с анемическим синдромом у детей, классификацией, диагностикой, клиникой и алгоритмами диагностики анемий у детей в зависимости от этиологии.
 Определение анемии: Анемия - патологическое уменьшение количества циркулирующих в крови эритроцитов, качественные их изменения, снижение уровней гемоглобина (Hb) и гематокрита (Ht).
Определение анемии: Анемия - патологическое уменьшение количества циркулирующих в крови эритроцитов, качественные их изменения, снижение уровней гемоглобина (Hb) и гематокрита (Ht).
 Анемии у детей Термин анемия без расшифровки не определяет конкретной болезни, это всего лишь констатация наличия группы признаков. При оценке конкретных случаев анемии важно представлять возрастные варианты картины крови.
Анемии у детей Термин анемия без расшифровки не определяет конкретной болезни, это всего лишь констатация наличия группы признаков. При оценке конкретных случаев анемии важно представлять возрастные варианты картины крови.
 Схема кроветворения По степени дифференцированности клетки костного мозга делят на 6 классов: I. Полипотентные клетки (стволовые клетки). II. Частично детерминированные клеткипредшественницы, включают в себя клетки, несущие более ограниченный запас информации, а именно: клетки-предшественницы лимфопоэза И клетки-предшественницы миелопоэза.
Схема кроветворения По степени дифференцированности клетки костного мозга делят на 6 классов: I. Полипотентные клетки (стволовые клетки). II. Частично детерминированные клеткипредшественницы, включают в себя клетки, несущие более ограниченный запас информации, а именно: клетки-предшественницы лимфопоэза И клетки-предшественницы миелопоэза.
 Схема кроветворения III. Унипотентные клетки-предшественницы, поэтинчувствительные, дающие начало одному из ростков кроветворения, в связи с чем различают: клетки-предшественницы эритропоэза, миелопоэза И тромбоцитопоэза.
Схема кроветворения III. Унипотентные клетки-предшественницы, поэтинчувствительные, дающие начало одному из ростков кроветворения, в связи с чем различают: клетки-предшественницы эритропоэза, миелопоэза И тромбоцитопоэза.
 Схема кроветворения IV. Морфологически распознаваемые пролифирирующие клетки, имеющие определенные морфологические признаки. V. Созревающие клетки, представленные всеми переходными формами. VI. Зрелые клетки: эритроциты, гранулоциты (нейтрофилы, эозинофилы, базофилы, моноциты), тромбоциты.
Схема кроветворения IV. Морфологически распознаваемые пролифирирующие клетки, имеющие определенные морфологические признаки. V. Созревающие клетки, представленные всеми переходными формами. VI. Зрелые клетки: эритроциты, гранулоциты (нейтрофилы, эозинофилы, базофилы, моноциты), тромбоциты.
 Схема кроветворения ЭП 3 ЛИ ИЛ-3 ИЛ- ФСК Flt-3 L ИЛ-3 ИЛ-6 ФСК Первичная стволовая клетка 3 ТПО ГМ-КСФ Г-КСФ ПМ -К СФ ЭП КОЕ-Э БОЕМК ТПО ГМ-КСФ КОЕ-Г ГМ-КСФ Эритроцит Тромбоцит Нейтрофил ИЛ-6 , ИЛ -7 Полипотентные клетки -предшественники ИЛ-3 Эозинофил КОЕБа ИЛ-6, ИЛ-7 ИЛ-5 КОЕЕо ИЛ-3 ИЛ-6 ИЛ-7 ФСК КОЕГМ ИЛ-6 Базофил ИЛ-2, ИЛ-4 В-лимфоцит КОЕ-В КОЕ-Т тимус Унипотентные клеткипредшественники Моноцит Т-лимфоцит Зрелые циркулирующие клетки
Схема кроветворения ЭП 3 ЛИ ИЛ-3 ИЛ- ФСК Flt-3 L ИЛ-3 ИЛ-6 ФСК Первичная стволовая клетка 3 ТПО ГМ-КСФ Г-КСФ ПМ -К СФ ЭП КОЕ-Э БОЕМК ТПО ГМ-КСФ КОЕ-Г ГМ-КСФ Эритроцит Тромбоцит Нейтрофил ИЛ-6 , ИЛ -7 Полипотентные клетки -предшественники ИЛ-3 Эозинофил КОЕБа ИЛ-6, ИЛ-7 ИЛ-5 КОЕЕо ИЛ-3 ИЛ-6 ИЛ-7 ФСК КОЕГМ ИЛ-6 Базофил ИЛ-2, ИЛ-4 В-лимфоцит КОЕ-В КОЕ-Т тимус Унипотентные клеткипредшественники Моноцит Т-лимфоцит Зрелые циркулирующие клетки
 Эритропоэз Клетками-предшественницами эритропоэза являются: 1. Бурстобразующая эритроидная единица (БОЕ-Э) - зрелая и незрелая 2. Смешанная гранулоцитарноэритроидная клетка предшественница (КОЕ-ГЭ).
Эритропоэз Клетками-предшественницами эритропоэза являются: 1. Бурстобразующая эритроидная единица (БОЕ-Э) - зрелая и незрелая 2. Смешанная гранулоцитарноэритроидная клетка предшественница (КОЕ-ГЭ).
 Эритропоэз Для пролиферации молодых клетокпредшественниц эритропоэза необходимо присутствие: n n n ГМ-КСФ; фактора стволовых клеток (ФСК); ИЛ-3. Возникающие в результате деления дифференцированные клеткипредшественницы эритропоэза постепенно утрачивают чувствительность к этим факторам и приобретают чувствительность к эритропоэтину.
Эритропоэз Для пролиферации молодых клетокпредшественниц эритропоэза необходимо присутствие: n n n ГМ-КСФ; фактора стволовых клеток (ФСК); ИЛ-3. Возникающие в результате деления дифференцированные клеткипредшественницы эритропоэза постепенно утрачивают чувствительность к этим факторам и приобретают чувствительность к эритропоэтину.
 Эритропоэз n Эритропоэтин - гормон гликопротеиновой природы; 90% его образуется в почках и синтезируется клетками юкстагломерулярного аппарата и эпителиальными клетками почечных клубочков. У здоровых людей уровень эритропоэтина в плазме варьирует в пределах 0, 01 -0, 03 МЕ/мкл, повышаясь в 100 -1000 раз при возникновении гипоксии любого генеза.
Эритропоэз n Эритропоэтин - гормон гликопротеиновой природы; 90% его образуется в почках и синтезируется клетками юкстагломерулярного аппарата и эпителиальными клетками почечных клубочков. У здоровых людей уровень эритропоэтина в плазме варьирует в пределах 0, 01 -0, 03 МЕ/мкл, повышаясь в 100 -1000 раз при возникновении гипоксии любого генеза.
 Эритропоэз Регулируют эритропоэз: витамины андрогены микроэлементы
Эритропоэз Регулируют эритропоэз: витамины андрогены микроэлементы
 Классификация Количество эритроцитов - менее объективный показатель анемии, не всегда коррелирует со степенью анемии. В общей практике основным критерием анемии и степени ее тяжести является показатель уровня гемоглобина: легкая степень - Hb 110 - 90 гр/л; средняя - Hb 90 - 70 гр/л; тяжелая - Hb менее 70 гр/л.
Классификация Количество эритроцитов - менее объективный показатель анемии, не всегда коррелирует со степенью анемии. В общей практике основным критерием анемии и степени ее тяжести является показатель уровня гемоглобина: легкая степень - Hb 110 - 90 гр/л; средняя - Hb 90 - 70 гр/л; тяжелая - Hb менее 70 гр/л.
 Классификация Анемии на основе среднего диаметра эритроцитов или объема эритроцитов подразделяются: Микроцитарные (СДЭ – менее 6, 9) Нормоцитарные (СДЭ – 7 - 7, 8) Макроцитарные (СДЭ – более 7, 8)
Классификация Анемии на основе среднего диаметра эритроцитов или объема эритроцитов подразделяются: Микроцитарные (СДЭ – менее 6, 9) Нормоцитарные (СДЭ – 7 - 7, 8) Макроцитарные (СДЭ – более 7, 8)
 Классификация Средний диаметр эритроцита (СДЭ) в норме - 7 -7, 8 мкм; Средний объем эритроцитов (MCV) – 80 - 93.
Классификация Средний диаметр эритроцита (СДЭ) в норме - 7 -7, 8 мкм; Средний объем эритроцитов (MCV) – 80 - 93.
 Классификация Микроцитарная анемия: n ЖДА (нарушения питания, кровопотеря). n отравления свинцом. n талассемия. n сидеробластная анемия. n хронические воспалительные n n заболевания. некоторые гемолитические анемии.
Классификация Микроцитарная анемия: n ЖДА (нарушения питания, кровопотеря). n отравления свинцом. n талассемия. n сидеробластная анемия. n хронические воспалительные n n заболевания. некоторые гемолитические анемии.
 Классификация Макроцитарные анемии: 1. С мегалобластическим гемопоэзом: n В 12 -дефицитная анемия; n фолиеводефицитная анемия; n наследственная оротатацидурия.
Классификация Макроцитарные анемии: 1. С мегалобластическим гемопоэзом: n В 12 -дефицитная анемия; n фолиеводефицитная анемия; n наследственная оротатацидурия.
 Классификация Макроцитарные анемии: 2. Без мегалобластического гемопоэза: n патология печени. n гипотиреоидизм n дефекты гемопоэза n приобретенная апластическая анемия n анемия Фанкони
Классификация Макроцитарные анемии: 2. Без мегалобластического гемопоэза: n патология печени. n гипотиреоидизм n дефекты гемопоэза n приобретенная апластическая анемия n анемия Фанкони
 Классификация Макроцитарные анемии: анемия Дайемонда-Блекфана миелодисплазия
Классификация Макроцитарные анемии: анемия Дайемонда-Блекфана миелодисплазия
 Классификация Нормоцитарные анемии: Гемолитические анемии: патология эритроцитарного окружения: 4 а) АТ-опосредованные; 4 б) микроангиопатические; 4 в) индуцированные токсинами; 4 г) индуцированные инфекциями;
Классификация Нормоцитарные анемии: Гемолитические анемии: патология эритроцитарного окружения: 4 а) АТ-опосредованные; 4 б) микроангиопатические; 4 в) индуцированные токсинами; 4 г) индуцированные инфекциями;
 Классификация Нормоцитарные анемии: Гемолитические анемии: Патология мембран эритроцитов: а)наследственный сфероцитоз; б) наследственный эллиптоцитоз; в)ПНГ.
Классификация Нормоцитарные анемии: Гемолитические анемии: Патология мембран эритроцитов: а)наследственный сфероцитоз; б) наследственный эллиптоцитоз; в)ПНГ.
 Классификация n n n Нормоцитарные анемии: Гемолитические анемии: Гемоглобинопатии: а) Hb. S; 4 b) Hb. C; 4 в) нестабильный Hb; 4 г) прочие гемоглобинопатии. 4
Классификация n n n Нормоцитарные анемии: Гемолитические анемии: Гемоглобинопатии: а) Hb. S; 4 b) Hb. C; 4 в) нестабильный Hb; 4 г) прочие гемоглобинопатии. 4
 Классификация n Нормоцитарные анемии: n Гемолитические анемии: n Энзимопатии: 4 а) недостаточность Г 6 ФД; 4 б) недостаточность ПК. n Кровотечения. n Гиперспленизм
Классификация n Нормоцитарные анемии: n Гемолитические анемии: n Энзимопатии: 4 а) недостаточность Г 6 ФД; 4 б) недостаточность ПК. n Кровотечения. n Гиперспленизм
 Классификация n Нормоцитарные анемии: Дефекты образования эритроцитарного пула: 4 а) эритроцитарная аплазия; 4 б) транзиторная детская; 4 в) лекарственная; 4 г) хроническая почечная патология.
Классификация n Нормоцитарные анемии: Дефекты образования эритроцитарного пула: 4 а) эритроцитарная аплазия; 4 б) транзиторная детская; 4 в) лекарственная; 4 г) хроническая почечная патология.
 Классификация n Нормоцитарные анемии: n Панцитопения: 4 4 n а) приобретенная апластическая анемия; б) анемия Фанкони. Перерождение костного мозга (например, при лейкозах).
Классификация n Нормоцитарные анемии: n Панцитопения: 4 4 n а) приобретенная апластическая анемия; б) анемия Фанкони. Перерождение костного мозга (например, при лейкозах).
 Классификация В настоящее время чаще используется патогенетическая класcификация (Алексеев Г. А. , 1970; Allan J. Erslev, 1995; Natan, Oski, 1998). I. Анемии, возникающие в результате острой кровопотери.
Классификация В настоящее время чаще используется патогенетическая класcификация (Алексеев Г. А. , 1970; Allan J. Erslev, 1995; Natan, Oski, 1998). I. Анемии, возникающие в результате острой кровопотери.
 Классификация II. Анемии, возникающие в результате дефицитного эритропоэза. II. I. За счет нарушения созревания (в основном микроцитарные): n нарушение всасывания и использования железа (ЖДА); n нарушение транспорта железа (атрансферринемия); n нарушение утилизации железа (талассемии, сидеробластные анемии); n нарушение реутилазации железа (анемии при хронических болезнях).
Классификация II. Анемии, возникающие в результате дефицитного эритропоэза. II. I. За счет нарушения созревания (в основном микроцитарные): n нарушение всасывания и использования железа (ЖДА); n нарушение транспорта железа (атрансферринемия); n нарушение утилизации железа (талассемии, сидеробластные анемии); n нарушение реутилазации железа (анемии при хронических болезнях).
 Классификация II. Анемии, возникающие в результате дефицитного эритропоэза. II. За счет нарушения дифференцировки (в основном нормоцитарные): n апластические анемии (врожденные и приобретенные); n врожденные дизэритропоэтические анемии. III. За счет нарушения пролиферации (в основном макроцитарные): n В-12 дефицитные анемии; n Фолиеводефицитные анемии.
Классификация II. Анемии, возникающие в результате дефицитного эритропоэза. II. За счет нарушения дифференцировки (в основном нормоцитарные): n апластические анемии (врожденные и приобретенные); n врожденные дизэритропоэтические анемии. III. За счет нарушения пролиферации (в основном макроцитарные): n В-12 дефицитные анемии; n Фолиеводефицитные анемии.
 Классификация III. Анемии, возникающие в результате повышенной деструкции клеток эритроидного ряда: III. I. Гемолиз, вызванный внутренними аномалиями эритроцитов: n мембранопатии; n энзимопатии; гемоглобинопатии. III. Гемолиз, вызванный внешним воздействием: n аутоиммунные гемолитические анемии; n травматические анемии; n пароксизмальная ночная гемоглобинопатия (ПНГ). n
Классификация III. Анемии, возникающие в результате повышенной деструкции клеток эритроидного ряда: III. I. Гемолиз, вызванный внутренними аномалиями эритроцитов: n мембранопатии; n энзимопатии; гемоглобинопатии. III. Гемолиз, вызванный внешним воздействием: n аутоиммунные гемолитические анемии; n травматические анемии; n пароксизмальная ночная гемоглобинопатия (ПНГ). n
 Классификация На основании цветового показателя: n n n гипохромные < 0, 85; нормохромные - 0, 85 -1, 05; гиперхромные > 1, 05.
Классификация На основании цветового показателя: n n n гипохромные < 0, 85; нормохромные - 0, 85 -1, 05; гиперхромные > 1, 05.
 Классификация По регенераторной функции костного мозга (по количеству ретикулоцитов): Норморегенераторные - 15 -50 %0, ретикулоцитарный индекс более 1, но не менее 2. Гиперрегенераторные: число ретикулоцитов более 50%0, ретикулоцитарный индекс – более 2.
Классификация По регенераторной функции костного мозга (по количеству ретикулоцитов): Норморегенераторные - 15 -50 %0, ретикулоцитарный индекс более 1, но не менее 2. Гиперрегенераторные: число ретикулоцитов более 50%0, ретикулоцитарный индекс – более 2.
 Классификация По регенераторной функции костного мозга (по количеству ретикулоцитов): Гипорегенераторные - низкий ретикулоцитоз, ретикулоцитарный индекс менее 1. Ретикулоцитарный индекс рассчитывается умножением величины показателя гематокрита на число ретикулоцитов (в %0) и делится на нормальный показатель гематокрита.
Классификация По регенераторной функции костного мозга (по количеству ретикулоцитов): Гипорегенераторные - низкий ретикулоцитоз, ретикулоцитарный индекс менее 1. Ретикулоцитарный индекс рассчитывается умножением величины показателя гематокрита на число ретикулоцитов (в %0) и делится на нормальный показатель гематокрита.
 Эритроцитарные индексы- MCV, MCHC, предложенны в 1929 году M. Wintrobe и до сегодняшнего дня не утратили своего диагностического значения. MCV - средний объем эритроцита в норме 80 - 93. MCH - среднее содержание гемоглобина в эритроците, в норме 27 - 31 пг.
Эритроцитарные индексы- MCV, MCHC, предложенны в 1929 году M. Wintrobe и до сегодняшнего дня не утратили своего диагностического значения. MCV - средний объем эритроцита в норме 80 - 93. MCH - среднее содержание гемоглобина в эритроците, в норме 27 - 31 пг.
 Эритроцитарные индексы MCHC - средняя концентрация гемоглобина в эритроците, в норме 33 - 37 г/дл. RDW - показатель анизоцитоза эритроцитов, в норме 11, 5 - 14, 5. Индекс Ментцера - это соотношение MCV к количеству эритроцитов. Он позволяет провести дифференциальную диагностику двух основных причин развития микроцитоза - ЖДА и гетерозиготной талассемии. Для ЖДА индекс Ментцера более 13, для талассемии - менее 13.
Эритроцитарные индексы MCHC - средняя концентрация гемоглобина в эритроците, в норме 33 - 37 г/дл. RDW - показатель анизоцитоза эритроцитов, в норме 11, 5 - 14, 5. Индекс Ментцера - это соотношение MCV к количеству эритроцитов. Он позволяет провести дифференциальную диагностику двух основных причин развития микроцитоза - ЖДА и гетерозиготной талассемии. Для ЖДА индекс Ментцера более 13, для талассемии - менее 13.
 Эритроцитарные индексы MCV меняется в течение жизни: у н/р может достигать 128 фл, в первую неделю снижается до 100 -112 фл, к году - 77 -79 фл, 4 -5 лет стабилизируется - нижняя граница 80 фл. Оценка этого показателя необходима для характеристики популяции эритроцитов, что важно для диагностики ЖДА и В 12 - дефицитных анемий. Относительное снижение MCV может быть следствием повышенного содержания фрагментов эритроцитов в крови (коагулопатии, механический гемолиз).
Эритроцитарные индексы MCV меняется в течение жизни: у н/р может достигать 128 фл, в первую неделю снижается до 100 -112 фл, к году - 77 -79 фл, 4 -5 лет стабилизируется - нижняя граница 80 фл. Оценка этого показателя необходима для характеристики популяции эритроцитов, что важно для диагностики ЖДА и В 12 - дефицитных анемий. Относительное снижение MCV может быть следствием повышенного содержания фрагментов эритроцитов в крови (коагулопатии, механический гемолиз).
 Эритроцитарные индексы MCН - делят анемии на нормо-, гипо- и гиперхромные. MCH - более объективный показатель, чем цветовой показатель, который не отражает синтез гемоглобина и его содержание в эритроците, а во многом зависит от объема эритроцита.
Эритроцитарные индексы MCН - делят анемии на нормо-, гипо- и гиперхромные. MCH - более объективный показатель, чем цветовой показатель, который не отражает синтез гемоглобина и его содержание в эритроците, а во многом зависит от объема эритроцита.
 Эитроцитарные индексы MCHC - снижение наблюдается при заболеваниях с нарушением синтеза гемоглобина. Наиболее гемоглобина стабильный гематологический показатель. Любая неточность, связанная с определением Hb, Ht, MCV, приводит к увеличению MCHC Этот параметр используется как индикатор ошибки прибора или ошибки, допущенной при подготовке пробы к исследованию.
Эитроцитарные индексы MCHC - снижение наблюдается при заболеваниях с нарушением синтеза гемоглобина. Наиболее гемоглобина стабильный гематологический показатель. Любая неточность, связанная с определением Hb, Ht, MCV, приводит к увеличению MCHC Этот параметр используется как индикатор ошибки прибора или ошибки, допущенной при подготовке пробы к исследованию.
 Клинические проявления n n n n Усталость, одышка, сильное сердцебиение, плохая переносимость физической нагрузки, головокружения, головная боль, шум в ушах.
Клинические проявления n n n n Усталость, одышка, сильное сердцебиение, плохая переносимость физической нагрузки, головокружения, головная боль, шум в ушах.
 Клинические проявления Тяжелая анемия вызывает: n анорексию, n расстройства пищеварения, n раздражительность, n нарушения сна, n затруднение концентрации внимания.
Клинические проявления Тяжелая анемия вызывает: n анорексию, n расстройства пищеварения, n раздражительность, n нарушения сна, n затруднение концентрации внимания.
 Клинические проявления У женщин возможны нарушения менструального цикла. Бледность - основной симптом анемии, легче всего ее можно определить по цвету: 1. Слизистой ротовой полости. 2. Ногтевого ложа. 3. Конъюктивы. 4. Складок ладоней.
Клинические проявления У женщин возможны нарушения менструального цикла. Бледность - основной симптом анемии, легче всего ее можно определить по цвету: 1. Слизистой ротовой полости. 2. Ногтевого ложа. 3. Конъюктивы. 4. Складок ладоней.
 Клинические проявления К другим физикальным симптомам анемии относят: 1. тахикардию, 2. усиленный сердечный толчок, 3. систолический шум. Анемия, вызванная гемолизом и гемоглобинопатиями, характеризуется желтухой и спленомегалией.
Клинические проявления К другим физикальным симптомам анемии относят: 1. тахикардию, 2. усиленный сердечный толчок, 3. систолический шум. Анемия, вызванная гемолизом и гемоглобинопатиями, характеризуется желтухой и спленомегалией.
 Диагностика анемии n n n анамнез и клинический осмотр пациента; наследственность; возраст больного; исследование периферической крови: общее количество клеток, эритроцитарные индексы, уровень ретикулоцитов, тромбоцитов, формула крови, морфология клеток крови; сравнение показателей периферической крови с возрастными нормами;
Диагностика анемии n n n анамнез и клинический осмотр пациента; наследственность; возраст больного; исследование периферической крови: общее количество клеток, эритроцитарные индексы, уровень ретикулоцитов, тромбоцитов, формула крови, морфология клеток крови; сравнение показателей периферической крови с возрастными нормами;
 Диагностика анемии n исследование костного мозга: n аспирация, n биопсия, микробиологическое и культуральное исследование, гистохимия, иммунофенотипирование, цитогенетическое и молекулярнобиологическое исследование; n инструментальные исследования (УЗИ, КТ, ЯМР, рентгенография).
Диагностика анемии n исследование костного мозга: n аспирация, n биопсия, микробиологическое и культуральное исследование, гистохимия, иммунофенотипирование, цитогенетическое и молекулярнобиологическое исследование; n инструментальные исследования (УЗИ, КТ, ЯМР, рентгенография).
 Диагностика анемии Лабораторные специфические исследования: n n n n 1. Необходимые: 1. 1. Общий анализ мочи, включая микроскопию. 1. 2. Анализ кала (скрытая кровь). 1. 3. Определение билирубина по фракциям. 1. 4. Азот, мочевина, креатинин. 1. 5. Проба Кумбса. 1. 6. Электофорез гемоглобина. 1. 7. Определение гаптоглобина.
Диагностика анемии Лабораторные специфические исследования: n n n n 1. Необходимые: 1. 1. Общий анализ мочи, включая микроскопию. 1. 2. Анализ кала (скрытая кровь). 1. 3. Определение билирубина по фракциям. 1. 4. Азот, мочевина, креатинин. 1. 5. Проба Кумбса. 1. 6. Электофорез гемоглобина. 1. 7. Определение гаптоглобина.
 Диагностика анемии 2. Дополнительные: n 2. 1. Сывороточное железо, ОЖСС. n 2. 2. Ферритин. n 2. 3. Уровень В 12, фолиевой кислоты. n 2. 4. Осмотическая резистентность эритроцитов. n 2. 5. Определение ферментов эритроцитов. n 2. 6. Количественное и качественное определение фетального гемоглобина.
Диагностика анемии 2. Дополнительные: n 2. 1. Сывороточное железо, ОЖСС. n 2. 2. Ферритин. n 2. 3. Уровень В 12, фолиевой кислоты. n 2. 4. Осмотическая резистентность эритроцитов. n 2. 5. Определение ферментов эритроцитов. n 2. 6. Количественное и качественное определение фетального гемоглобина.
 Диагностика анемии n n n 2. 7. Определение нестабильности эритроцитов. 2. 8. Проба Хема. 2. 9. Радиоизотопное исследование с хромом. 2. 10. Иммунология. 2. 11. Серология (парвовирус В 19, ВЭБ, ЦМВ и др. ). 2. 12. ПЦР.
Диагностика анемии n n n 2. 7. Определение нестабильности эритроцитов. 2. 8. Проба Хема. 2. 9. Радиоизотопное исследование с хромом. 2. 10. Иммунология. 2. 11. Серология (парвовирус В 19, ВЭБ, ЦМВ и др. ). 2. 12. ПЦР.
 Использование MCV и ретикулоцитов для дифф. диагностики анемии АНЕМИЯ MCV
Использование MCV и ретикулоцитов для дифф. диагностики анемии АНЕМИЯ MCV
 Использование MCV и ретикулоцитов для дифф. диагностики анемии MCV Снижение: ЖДА, талассемия, отравления свинцом, хронические заболевания Повышен: дефицит фолатов, В 12, АА, МДС, иммунная ГА, заболевания печени
Использование MCV и ретикулоцитов для дифф. диагностики анемии MCV Снижение: ЖДА, талассемия, отравления свинцом, хронические заболевания Повышен: дефицит фолатов, В 12, АА, МДС, иммунная ГА, заболевания печени
 Использование MCV и ретикулоцитов для дифф. диагностики анемии АНЕМИЯ РЕТИКУЛОЦИТЫ
Использование MCV и ретикулоцитов для дифф. диагностики анемии АНЕМИЯ РЕТИКУЛОЦИТЫ
 Использование MCV и ретикулоцитов для дифф. диагностики анемии Ретикулоциты - высокие билирубин нормальный кровотечение
Использование MCV и ретикулоцитов для дифф. диагностики анемии Ретикулоциты - высокие билирубин нормальный кровотечение
 Использование MCV и ретикулоцитов для дифф. диагностики анемии Ретикулоциты - высокие билирубин высокий ГА
Использование MCV и ретикулоцитов для дифф. диагностики анемии Ретикулоциты - высокие билирубин высокий ГА
 Использование MCV и ретикулоцитов для дифф. диагностики анемии ГА Проба Кумбса отрицательная положительная
Использование MCV и ретикулоцитов для дифф. диагностики анемии ГА Проба Кумбса отрицательная положительная
 Использование MCV и ретикулоцитов для дифф. диагностики анемии отрицательная Мембранопатии, ферментопатии, гемоглобинопатии, микроангиоптаические ГА, вторичные ГА (инфекции, лекарства). положительная Аутоиммунная ГА: первичная, вторичная (лекарственная), изоиммунная ГА, переливание несовместимой крови
Использование MCV и ретикулоцитов для дифф. диагностики анемии отрицательная Мембранопатии, ферментопатии, гемоглобинопатии, микроангиоптаические ГА, вторичные ГА (инфекции, лекарства). положительная Аутоиммунная ГА: первичная, вторичная (лекарственная), изоиммунная ГА, переливание несовместимой крови
 Использование MCV и ретикулоцитов для дифф. диагностики анемии ретикулоциты снижены Количество лейкоцитов и тромбоцитов
Использование MCV и ретикулоцитов для дифф. диагностики анемии ретикулоциты снижены Количество лейкоцитов и тромбоцитов
 Использование MCV и ретикулоцитов для дифф. диагностики анемии Лейкоциты и тромбоциты снижены Депрессия костного мозга; опухоли; АА (анемия Фанкони, приобретенные)
Использование MCV и ретикулоцитов для дифф. диагностики анемии Лейкоциты и тромбоциты снижены Депрессия костного мозга; опухоли; АА (анемия Фанкони, приобретенные)
 Использование MCV и ретикулоцитов для дифф. диагностики анемии Лейкоциты и тромбоциты нормальное Анемия Блекфана-Даймонда, транзиторная эритробластпения.
Использование MCV и ретикулоцитов для дифф. диагностики анемии Лейкоциты и тромбоциты нормальное Анемия Блекфана-Даймонда, транзиторная эритробластпения.
 Использование MCV и ретикулоцитов для дифф. диагностики анемии Лейкоциты и тромбоциты повышенное Острые инфекции
Использование MCV и ретикулоцитов для дифф. диагностики анемии Лейкоциты и тромбоциты повышенное Острые инфекции
 Использование MCV и ретикулоцитов для дифф. диагностики анемии n Автор - Lanzkowsky P. , 2000 г.
Использование MCV и ретикулоцитов для дифф. диагностики анемии n Автор - Lanzkowsky P. , 2000 г.
 Алгоритмы диагностики анемий n I. Этапы диагностики: n 1. 1. Установление синдрома анемии: n n а)субъективные критерии - общие клинические (бледность кожных покровов и видимых слизистых, физическая и умственная утомляемость, сердечно-сосудистые нарушения); б) объективные критерии – снижение уровня гемоглобина менее 110 гр/л у детей до 5 лет, менее 120 гр/л - у женщин и менее 130 гр/л - у мужчин; возможно падение величины гематокрита ниже 35% у детей, ниже 37% - у женщин и ниже 42% - у мужчин.
Алгоритмы диагностики анемий n I. Этапы диагностики: n 1. 1. Установление синдрома анемии: n n а)субъективные критерии - общие клинические (бледность кожных покровов и видимых слизистых, физическая и умственная утомляемость, сердечно-сосудистые нарушения); б) объективные критерии – снижение уровня гемоглобина менее 110 гр/л у детей до 5 лет, менее 120 гр/л - у женщин и менее 130 гр/л - у мужчин; возможно падение величины гематокрита ниже 35% у детей, ниже 37% - у женщин и ниже 42% - у мужчин.
 Алгоритмы диагностики анемий n n 1. 2. Оценка тяжести анемий. 1. 3. Определение этиопатогенетической формы анемии. Состоит из двух этапов.
Алгоритмы диагностики анемий n n 1. 2. Оценка тяжести анемий. 1. 3. Определение этиопатогенетической формы анемии. Состоит из двух этапов.
 Алгоритмы диагностики анемий 1 этап включает: n 1. 1. Сбор анамнеза заболевания; n 1. 2. Клинический анализ крови с подсчетом ретикулоцитов и подробным описанием морфологии эритроцитов; n 1. 3. Эритроцитарные индексы; n 1. 4. Биохимический анализ крови (билирубин прямой и непрямой, ЛДГ, Ас. АТ, Ал. АТ (как показатели цитолиза), свободный гемоглобин, ЩФ).
Алгоритмы диагностики анемий 1 этап включает: n 1. 1. Сбор анамнеза заболевания; n 1. 2. Клинический анализ крови с подсчетом ретикулоцитов и подробным описанием морфологии эритроцитов; n 1. 3. Эритроцитарные индексы; n 1. 4. Биохимический анализ крови (билирубин прямой и непрямой, ЛДГ, Ас. АТ, Ал. АТ (как показатели цитолиза), свободный гемоглобин, ЩФ).
 Алгоритмы диагностики анемий n n n При установлении диагноза в группе микроцитарных анемий необходимо обратить внимание на количество эритроцитов. Если количество эритроцитов более 5 х 10 12/л талассемия (электрофорез гемоглобинов); менее 5 х 10 12/л - дифф. диагностика между - ЖДА и анемией хронических заболеваний. В группе макроцитарных анемий (в зависимости от анамнеза, клинических проявлений) второй этап обследования начинают с проведения пробы Кумбса.
Алгоритмы диагностики анемий n n n При установлении диагноза в группе микроцитарных анемий необходимо обратить внимание на количество эритроцитов. Если количество эритроцитов более 5 х 10 12/л талассемия (электрофорез гемоглобинов); менее 5 х 10 12/л - дифф. диагностика между - ЖДА и анемией хронических заболеваний. В группе макроцитарных анемий (в зависимости от анамнеза, клинических проявлений) второй этап обследования начинают с проведения пробы Кумбса.
 Алгоритмы диагностики анемий n n n При отрицательной пробе Кумбса - определяют концентрацию фолатов и В 12, проводят пункцию костного мозга. При подозрении на АА: пункция костного мозга из трех анатомических точек, трепанобиопсия, проба на ломкость хромосом, при сочетании АА и гемолиза - проба Хема. Наибольшие трудности представляет группа нормоцитарных анемий. В первую очередь необходимо установить или отвергнуть факт гемолиза.
Алгоритмы диагностики анемий n n n При отрицательной пробе Кумбса - определяют концентрацию фолатов и В 12, проводят пункцию костного мозга. При подозрении на АА: пункция костного мозга из трех анатомических точек, трепанобиопсия, проба на ломкость хромосом, при сочетании АА и гемолиза - проба Хема. Наибольшие трудности представляет группа нормоцитарных анемий. В первую очередь необходимо установить или отвергнуть факт гемолиза.
 Алгоритмы диагностики анемий Клинические проявления гемолиза: n 1. Желтуха; n 2. Увеличение селезенки и реже - печени. n 3. Темный цвет мочи (при внутрисосудистом гемолизе) и кала. n 4. Повышение числа ретикулоцитов. n 5. Уровня непрямого билирубина. n 6. Повышение 1 и 2 фракций ЛДГ. n 7. Повышение уробилиногена мочи. n 8. Снижение гаптоглобина
Алгоритмы диагностики анемий Клинические проявления гемолиза: n 1. Желтуха; n 2. Увеличение селезенки и реже - печени. n 3. Темный цвет мочи (при внутрисосудистом гемолизе) и кала. n 4. Повышение числа ретикулоцитов. n 5. Уровня непрямого билирубина. n 6. Повышение 1 и 2 фракций ЛДГ. n 7. Повышение уробилиногена мочи. n 8. Снижение гаптоглобина
 Алгоритмы диагностики анемий n n n (внутриклеточный гемолиз) Для внутрисосудистого - доминирующим является повышение свободного гемоглобина плазмы и гемоглобинурия, которые регистрируются в течение первых 8 -20 часов гемолиза и вышеперечисленные признаки. Следует отметить, что уровень билирубина может быть нормальным при компенсированном гемолизе и интенсивном диурезе.
Алгоритмы диагностики анемий n n n (внутриклеточный гемолиз) Для внутрисосудистого - доминирующим является повышение свободного гемоглобина плазмы и гемоглобинурия, которые регистрируются в течение первых 8 -20 часов гемолиза и вышеперечисленные признаки. Следует отметить, что уровень билирубина может быть нормальным при компенсированном гемолизе и интенсивном диурезе.
 Алгоритмы диагностики анемий Морфологическое описание эритроцитов дает следующую информацию: 1. Появление сфероцитов характерно: n а) наследственного сфероцитоза; n б) АИГА; n в) момент криза при дефиците Г-6 -ФД; n г) анемии при нестабилном гемоглобине (в зависимости от анамнеза и биохимических исследованиях делают пробу Кумбса, ОРЭ, определяют тельца Гейнца, активность Г-6 -ФД, проводят тесты на стабильность гемоглобина).
Алгоритмы диагностики анемий Морфологическое описание эритроцитов дает следующую информацию: 1. Появление сфероцитов характерно: n а) наследственного сфероцитоза; n б) АИГА; n в) момент криза при дефиците Г-6 -ФД; n г) анемии при нестабилном гемоглобине (в зависимости от анамнеза и биохимических исследованиях делают пробу Кумбса, ОРЭ, определяют тельца Гейнца, активность Г-6 -ФД, проводят тесты на стабильность гемоглобина).
Сфероциты
Сфероциты
 Алгоритмы диагностики анемий 2. Эллиптоциты: n а)наследственный эллиптоцитоз; n б) намного реже ЖДА; n в)мегалобластная анемия; n г)миелофиброз; n д) МДС; n ж) дефицит пируваткиназы.
Алгоритмы диагностики анемий 2. Эллиптоциты: n а)наследственный эллиптоцитоз; n б) намного реже ЖДА; n в)мегалобластная анемия; n г)миелофиброз; n д) МДС; n ж) дефицит пируваткиназы.
Элиптоциты
Элиптоциты
 Алгоритмы диагностики анемий 3. Серповидные клетки серповидноклеточная болезнь. 4. Мишеневидные клетки: n а) талассемия; n б) гемоглобин С; n в) заболевания печени (предполагает проведение электрофореза гемоглобинов, исследование функции печени).
Алгоритмы диагностики анемий 3. Серповидные клетки серповидноклеточная болезнь. 4. Мишеневидные клетки: n а) талассемия; n б) гемоглобин С; n в) заболевания печени (предполагает проведение электрофореза гемоглобинов, исследование функции печени).
 Алгоритмы диагностики анемий 5. Шизоциты: n а) тромботические микроангиопатические ГА; n б) иммунные васкулиты; n в)поврежденные сердечные клапаны; n г) эклампсия; n д) маршевая гемоглобинурия; n ж) тяжелые травмы; n з) тяжелые гемолитические кризы;
Алгоритмы диагностики анемий 5. Шизоциты: n а) тромботические микроангиопатические ГА; n б) иммунные васкулиты; n в)поврежденные сердечные клапаны; n г) эклампсия; n д) маршевая гемоглобинурия; n ж) тяжелые травмы; n з) тяжелые гемолитические кризы;
Шистоциты
Шистоциты
 Алгоритмы диагностики анемий 6. Акантоциты: n а) заболевания печени; n б) абета-липопротеинемия. 7. Стоматоциты: n а) врожденный и приобретенный стоматоцитоз.
Алгоритмы диагностики анемий 6. Акантоциты: n а) заболевания печени; n б) абета-липопротеинемия. 7. Стоматоциты: n а) врожденный и приобретенный стоматоцитоз.
 Акантоциты
Акантоциты
 Алгоритмы диагностики n Ядерные эритроциты — отклонение от нормы после первой недели жизни и встречаются при следующих состояниях: n n 1. н/р ( первые 3 -4 дня); 2. интенсивная стимуляция костного мозга; 3. гипоксия ( особенно после остановки сердца); 4. острая кровопотеря;
Алгоритмы диагностики n Ядерные эритроциты — отклонение от нормы после первой недели жизни и встречаются при следующих состояниях: n n 1. н/р ( первые 3 -4 дня); 2. интенсивная стимуляция костного мозга; 3. гипоксия ( особенно после остановки сердца); 4. острая кровопотеря;
 Алгоритмы диагностики n n тяжелые гемолитические анемии (талассемия, гемоглобинопатияя SS); врожденные инфекции (сепсис, сифилис, ЦМВ, краснуха); постспленэктомия или гипоспленические состояния; лейкоэритробластпенические реакции (описаны с экстрамедулярным гематопоэзом и замещением костного мозга;
Алгоритмы диагностики n n тяжелые гемолитические анемии (талассемия, гемоглобинопатияя SS); врожденные инфекции (сепсис, сифилис, ЦМВ, краснуха); постспленэктомия или гипоспленические состояния; лейкоэритробластпенические реакции (описаны с экстрамедулярным гематопоэзом и замещением костного мозга;
 Алгоритмы диагностики n n n очень часто при лейкозах и солидных опухолях — грибковые и микобактериальные инфекции, 10 000 — 20 000 лейкоцитов с малым или умеренным количеством метамиелоцитов, промиелоцитов, тромбоцитозом с широкими причудливыми тромбоцитами); мегалобластные анемии; дизэритпропоэтические анемии.
Алгоритмы диагностики n n n очень часто при лейкозах и солидных опухолях — грибковые и микобактериальные инфекции, 10 000 — 20 000 лейкоцитов с малым или умеренным количеством метамиелоцитов, промиелоцитов, тромбоцитозом с широкими причудливыми тромбоцитами); мегалобластные анемии; дизэритпропоэтические анемии.
 Алгоритмы диагностики n n Вытянутые эритроциты представляют собой эритроциты в форме вытянутых клеток и встречаются при следующих состояниях: дефицит Г 6 ФДГ ( в течение гемолитического криза); гемоглобинопатия SS; легочная эмболия.
Алгоритмы диагностики n n Вытянутые эритроциты представляют собой эритроциты в форме вытянутых клеток и встречаются при следующих состояниях: дефицит Г 6 ФДГ ( в течение гемолитического криза); гемоглобинопатия SS; легочная эмболия.
 Алгоритмы диагностики n n Базофильная пунктация в эритроцитах характерна для следующих состояний: гемолитические анемии (талассемия); ЖДА; отравления свинцом.
Алгоритмы диагностики n n Базофильная пунктация в эритроцитах характерна для следующих состояний: гемолитические анемии (талассемия); ЖДА; отравления свинцом.
 Алгоритмы диагностики n Кольца Кебота полные или неполные кольца либо восьмеркообразная фигура, могут быть представлены гранулами красновато-серого цвета. Образуются из митотических нитей или ядерной мембраны. Обнаруживаются при мегалобластной анемии.
Алгоритмы диагностики n Кольца Кебота полные или неполные кольца либо восьмеркообразная фигура, могут быть представлены гранулами красновато-серого цвета. Образуются из митотических нитей или ядерной мембраны. Обнаруживаются при мегалобластной анемии.
Тельца Кебота
Тельца Кебота
 Алгоритмы диагностики n n n Тельца Жолли в эритроцитах характерны для следующих состояний: постспленэктомии и гипосплении; н/р; мегалобластной анемии; дизэритропоэтических анемии; различные другие типы анемий (редко ЖДА, наследственный сфероцитоз).
Алгоритмы диагностики n n n Тельца Жолли в эритроцитах характерны для следующих состояний: постспленэктомии и гипосплении; н/р; мегалобластной анемии; дизэритропоэтических анемии; различные другие типы анемий (редко ЖДА, наследственный сфероцитоз).
Тельца Жолли
Тельца Жолли
 Алгоритмы диагностики анемий 1. 4. Характеристика тяжести течения анемии в динамике. n При решении вопроса о гемотрансфузии следует оценивать индивидуально с учетом прежде всего клинических, а не лабораторных показателей. n Отсутствие клинических симптомов и отрицательной динамики, характеризующих анемическую гипоксию, трансфузий не требует. n При анемиях, сопутствующих острым или хроническим заболеваниям, прежде всего стоит вопрос не о гемотрансфузионной терапии, а о лечении основного заболевания.
Алгоритмы диагностики анемий 1. 4. Характеристика тяжести течения анемии в динамике. n При решении вопроса о гемотрансфузии следует оценивать индивидуально с учетом прежде всего клинических, а не лабораторных показателей. n Отсутствие клинических симптомов и отрицательной динамики, характеризующих анемическую гипоксию, трансфузий не требует. n При анемиях, сопутствующих острым или хроническим заболеваниям, прежде всего стоит вопрос не о гемотрансфузионной терапии, а о лечении основного заболевания.
 Общие принципы и показания к трансфузиям Основные показания к трансфузиям эритроцитарной массы при хронических анемиях у детей: 1. Предупреждение и купирование тканевой, П органной гипоксии, обусловленной уменьшением массы эритроцитов (острым или хроническим); 2. Снижение (подавление) эритропоэза.
Общие принципы и показания к трансфузиям Основные показания к трансфузиям эритроцитарной массы при хронических анемиях у детей: 1. Предупреждение и купирование тканевой, П органной гипоксии, обусловленной уменьшением массы эритроцитов (острым или хроническим); 2. Снижение (подавление) эритропоэза.
 Общие принципы и показания к трансфузиям Анемии при заболеваниях внутренних органов: n Показанием для переливания эритроцитарной массы является неэффективность альтернативных методов лечения в случаях глубокой анемии (Hb<70 гр/л) или критических клинических проявлениях анемической гипоксии или сопутствующих кровотечениях в дозе 10 мл/кг.
Общие принципы и показания к трансфузиям Анемии при заболеваниях внутренних органов: n Показанием для переливания эритроцитарной массы является неэффективность альтернативных методов лечения в случаях глубокой анемии (Hb<70 гр/л) или критических клинических проявлениях анемической гипоксии или сопутствующих кровотечениях в дозе 10 мл/кг.
 Общие принципы и показания к трансфузиям Решение о показаниях к гемотрансфузиям у детей основывается не на показателях Hb и Ht, а на следующих факторах: 1) наличии или отсутствии клинических признаков и симптомов анемии; 2) этиологии анемии и ее динамики; 3) возможность использования вместо гемотрансфузий альтернативной терапии (эритропоэтин, препараты железа); 4) наличие или отсутствие сердечно-легочной недостаточности или заболеваний и нарушений со стороны цнс.
Общие принципы и показания к трансфузиям Решение о показаниях к гемотрансфузиям у детей основывается не на показателях Hb и Ht, а на следующих факторах: 1) наличии или отсутствии клинических признаков и симптомов анемии; 2) этиологии анемии и ее динамики; 3) возможность использования вместо гемотрансфузий альтернативной терапии (эритропоэтин, препараты железа); 4) наличие или отсутствие сердечно-легочной недостаточности или заболеваний и нарушений со стороны цнс.
 Общие принципы и показания к трансфузиям n n n Необоснованно назначение эритроцитов для «улучшения состояния ребенка» , «повышения его питания» , «улучшения заживления ран» , для «стимуляции защитных сил организма» . Дети более толерантны к анемиям, чем взрослые, отчасти из-за большого сердечно-легочного резерва и отсутствия коронарных заболеваний. Организм ребенка сравнительно быстро компенсирует потерю кислородотранспортной способности посредством смещения кислороддиссоционной кривой впарво; снижения сродства Hb к кислороду; увеличения сердечного выброса не происходит, пока концентрация Hb не станет ниже 70 гр/л
Общие принципы и показания к трансфузиям n n n Необоснованно назначение эритроцитов для «улучшения состояния ребенка» , «повышения его питания» , «улучшения заживления ран» , для «стимуляции защитных сил организма» . Дети более толерантны к анемиям, чем взрослые, отчасти из-за большого сердечно-легочного резерва и отсутствия коронарных заболеваний. Организм ребенка сравнительно быстро компенсирует потерю кислородотранспортной способности посредством смещения кислороддиссоционной кривой впарво; снижения сродства Hb к кислороду; увеличения сердечного выброса не происходит, пока концентрация Hb не станет ниже 70 гр/л
 Общие принципы и показания к трансфузиям n n (Hume H. , 1991; Kevy S. , 1993). В связи с этим у детей уровень Hb в меньшей степени, чем у взрослых, может служить показателем необходимости гемотрансфузии. Хроническая анемия у детей обычно развивается медленно и нередко протекает бессимптомно, несмотря на уровень Hb 80 гр/л и даже 70 гр/л. Например, ЖДА у детей можно лечить одним железом, даже при очень низком уровне Hb (Hume H. , 1989).
Общие принципы и показания к трансфузиям n n (Hume H. , 1991; Kevy S. , 1993). В связи с этим у детей уровень Hb в меньшей степени, чем у взрослых, может служить показателем необходимости гемотрансфузии. Хроническая анемия у детей обычно развивается медленно и нередко протекает бессимптомно, несмотря на уровень Hb 80 гр/л и даже 70 гр/л. Например, ЖДА у детей можно лечить одним железом, даже при очень низком уровне Hb (Hume H. , 1989).
 Общие принципы и показания к трансфузиям n n Трансфузионная терапия эритроцитами требуется при хронических анемических состояниях только в исключительных случаях. Как правило для детей лучше применять эритроцитарную массу обедненную лейкоцитами: больные с анемиями, имеющие показания к повторным множественным гемотрансфузиям (для профилактики аллоиммунизации, негемолитичесих реакций);
Общие принципы и показания к трансфузиям n n Трансфузионная терапия эритроцитами требуется при хронических анемических состояниях только в исключительных случаях. Как правило для детей лучше применять эритроцитарную массу обедненную лейкоцитами: больные с анемиями, имеющие показания к повторным множественным гемотрансфузиям (для профилактики аллоиммунизации, негемолитичесих реакций);
 Общие принципы и показания к трансфузиям n n n больные, имеющие в анамнезе посттрансфузионные реакции на переливание крови или ее компонентов; больные, отвечающие на гемотрансфузии аллергическими или реактивными реакциями (уртикарная сыпь, эритема, озноб (температура), беспокойства); наличие у больных гиперчувствительности и реакций на вводимые белки; больные с аллоиммунизацией или угрозой ее развития; больные с угрозой развития иммуносупрессии, послеоперационных инфекционных осложнений;
Общие принципы и показания к трансфузиям n n n больные, имеющие в анамнезе посттрансфузионные реакции на переливание крови или ее компонентов; больные, отвечающие на гемотрансфузии аллергическими или реактивными реакциями (уртикарная сыпь, эритема, озноб (температура), беспокойства); наличие у больных гиперчувствительности и реакций на вводимые белки; больные с аллоиммунизацией или угрозой ее развития; больные с угрозой развития иммуносупрессии, послеоперационных инфекционных осложнений;
 Общие принципы и показания к трансфузиям n n n больные с апластическими анемиями, гемоглобинопатиями (талассемия, серповидноклеточная анемия); серонегативные цитомегаловирусные больные; для профилактики ЦМВ-инфекции; кандидаты на транспалтанцию костного мозга или органов; больные с иммунодефицитом и серонегативные к ЦМВ; больные с лейкоцитарными антигенами.
Общие принципы и показания к трансфузиям n n n больные с апластическими анемиями, гемоглобинопатиями (талассемия, серповидноклеточная анемия); серонегативные цитомегаловирусные больные; для профилактики ЦМВ-инфекции; кандидаты на транспалтанцию костного мозга или органов; больные с иммунодефицитом и серонегативные к ЦМВ; больные с лейкоцитарными антигенами.
 Общие принципы и показания к трансфузиям n n Особенности длительной трансфузионной терапии у детей: Не использовать для трансфузий цельную кровь; Производить гемотрансфузии эритроцитарной массы при определенных показаниях с целью предупреждения клинически выраженной анемической гипоксии, обеспечения нормального роста и развития ребенка;
Общие принципы и показания к трансфузиям n n Особенности длительной трансфузионной терапии у детей: Не использовать для трансфузий цельную кровь; Производить гемотрансфузии эритроцитарной массы при определенных показаниях с целью предупреждения клинически выраженной анемической гипоксии, обеспечения нормального роста и развития ребенка;
 Общие принципы и показания к трансфузиям n n Избегать неоправданных трансфузий только на основании показателей Hb, Ht, эритроцитов; Устанавливать клинические симптомы и признаки, обусловленные анемией и их купирование после трансфузий для суждения об эффективности гемотерапии.
Общие принципы и показания к трансфузиям n n Избегать неоправданных трансфузий только на основании показателей Hb, Ht, эритроцитов; Устанавливать клинические симптомы и признаки, обусловленные анемией и их купирование после трансфузий для суждения об эффективности гемотерапии.
 Общие принципы и показания к трансфузиям n Для пердупреждения аллоиммунизации и посттрансфузионных реакций осуществлять трансфузии эритроцитов со сроком хранения до 7 дней (лучше 3 дня), совместимых по антигенам АВО и резус-фактора, с учетом наличия антител в крови донора и реципиента, с предварительным проведением непрямой пробы Кумбса; использовать для трансфузий эритроцитарную массу, обедненную лейкоцитами методом лейкофильтрации.
Общие принципы и показания к трансфузиям n Для пердупреждения аллоиммунизации и посттрансфузионных реакций осуществлять трансфузии эритроцитов со сроком хранения до 7 дней (лучше 3 дня), совместимых по антигенам АВО и резус-фактора, с учетом наличия антител в крови донора и реципиента, с предварительным проведением непрямой пробы Кумбса; использовать для трансфузий эритроцитарную массу, обедненную лейкоцитами методом лейкофильтрации.
 Общие принципы и показания к трансфузиям n n Своевременно диагностировать аллоиммунизацию по серологическим (наличие антител) и клиническим данным (посттрансфузионные реакции, отсутствие лечебной эффективности) для своевременного индивидуального подбора донорской крови. Оценивать посттрансфузионные реакции и эффективность гемотерапии путем клинического наблюдения, измерения температуры и мониторинга пред- и посттрансфузионного гематокрита, уровня гемоглобина.
Общие принципы и показания к трансфузиям n n Своевременно диагностировать аллоиммунизацию по серологическим (наличие антител) и клиническим данным (посттрансфузионные реакции, отсутствие лечебной эффективности) для своевременного индивидуального подбора донорской крови. Оценивать посттрансфузионные реакции и эффективность гемотерапии путем клинического наблюдения, измерения температуры и мониторинга пред- и посттрансфузионного гематокрита, уровня гемоглобина.
 Общие принципы и показания к трансфузиям Расчет объема переливаемой крови: 1. ОЦК: у новорожденного - 100 мл/кг; n у детей старше месяца- 80 мл/кг; n у взрослых - 65 мл/кг. 2. Объем эритроцитарной массы= ОЦК х Ht. 3. Переливание эритроцитарной массы: n объем переливаемой эритроцитарной массы, мл= (Ht треб. - Ht исх. ) x (ОЦК: Ht перел. ) n Пример: у ребенка с ОЦК 1800 мл нужно поднять Ht с 20% до 35% с помощью эритроцитарной массы с Ht=75%. n Объем переливаемой эритроцитарной массы= (35 -20) х (1800 : 75)= (15 х 1800) : 75= 360 мл.
Общие принципы и показания к трансфузиям Расчет объема переливаемой крови: 1. ОЦК: у новорожденного - 100 мл/кг; n у детей старше месяца- 80 мл/кг; n у взрослых - 65 мл/кг. 2. Объем эритроцитарной массы= ОЦК х Ht. 3. Переливание эритроцитарной массы: n объем переливаемой эритроцитарной массы, мл= (Ht треб. - Ht исх. ) x (ОЦК: Ht перел. ) n Пример: у ребенка с ОЦК 1800 мл нужно поднять Ht с 20% до 35% с помощью эритроцитарной массы с Ht=75%. n Объем переливаемой эритроцитарной массы= (35 -20) х (1800 : 75)= (15 х 1800) : 75= 360 мл.


